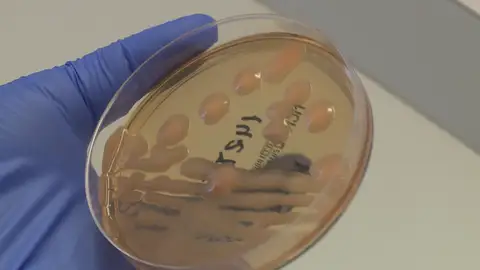
La sepsis, la infección bacteriana frecuente pero desconocida La sepsis, la infección bacteriana frecuente pero desconocida
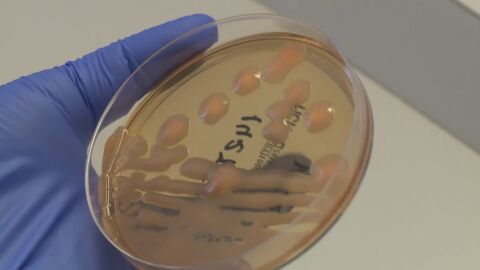
La sepsis, la infecci&oacute;n bacteriana frecuente pero desconocida

LA CLAVE, DETECTARLO A TIEMPO
La sepsis, la infección bacteriana frecuente pero desconocida
En España cada año mueren 17.000 personas por sepsis. Una enfermedad desconocida pero muy frecuente. Cualquier infección puede desencadenarla.
Publicidad
Nuestro organismo dispone de defensas que normalmente combaten cualquier infección, pero algunas veces no es capaz de defenderse por lo que existen bacterias que se expanden por todo el cuerpo dañando tejidos y órganos. Esta infección puede generar un fallo multiorgánico que puede llevar a la muerte. Se trata de una respuesta descompensada del cuerpo a una infección, es lo que se conoce como 'sepsis'.
Las sepsis más frecuentes son las respiratorias, las infecciones urinarias y las infecciones intrabdominales. Fiebre y fatiga son sus primeros síntomas que son similares a los de las enfermedades más frecuentes.Aunque existen grupos de riesgo, cualquiera puede contraerla. Sin embargo, es muy desconocida por lo que lo más importante es cogerla a tiempo.
Los hospitales siguen desarrollando herramientas que detecten la sepsis lo antes posible. El objetivo: concienciar y acabar con la primera causa de muerte evitable en el mundo.
Publicidad









